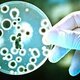
0

-
 La microbiología comenzó como una superstición, una especulación, se creía que las enfermedades bacterianas ocurrían por un castigo divino. Antes de que existiera el microscopio.
La microbiología comenzó como una superstición, una especulación, se creía que las enfermedades bacterianas ocurrían por un castigo divino. Antes de que existiera el microscopio. -
 A mediados del siglo XVII el comerciante de telas holandés, tendría una gran revelación al notar que dentro de su eyaculación encontraría unos "animálculos" retorciéndose por medio de un microscopio rudimentario de aquella época. Dando así uno de los grandes pasos para los inicios de la microbiología.
A mediados del siglo XVII el comerciante de telas holandés, tendría una gran revelación al notar que dentro de su eyaculación encontraría unos "animálculos" retorciéndose por medio de un microscopio rudimentario de aquella época. Dando así uno de los grandes pasos para los inicios de la microbiología. -
 Más conocido como Eugenio Espejo, desarrolló planes y medidas en contra de la viruela, ya que este analizaba por las calles de Ecuador las terribles epidemias que lo rodeaban. A través de su análisis descubrió que la enfermedad se propagaba en lugares donde asistían muchas personas, por lo tanto llegó a la conclusión que la gente se enfermaba por "corpúsculos", y no por el aire, los cuales eran microorganismos.
Más conocido como Eugenio Espejo, desarrolló planes y medidas en contra de la viruela, ya que este analizaba por las calles de Ecuador las terribles epidemias que lo rodeaban. A través de su análisis descubrió que la enfermedad se propagaba en lugares donde asistían muchas personas, por lo tanto llegó a la conclusión que la gente se enfermaba por "corpúsculos", y no por el aire, los cuales eran microorganismos. -
 Físico, químico y bacteriólogo francés, considerado el padre de la microbiología médica, se le atribuyen muchos descubrimientos innovadores, para la salud del ser humano y el conocimiento de la microbiología. Uno de sus descubrimientos más importantes, el proceso de la pasteurización.
Físico, químico y bacteriólogo francés, considerado el padre de la microbiología médica, se le atribuyen muchos descubrimientos innovadores, para la salud del ser humano y el conocimiento de la microbiología. Uno de sus descubrimientos más importantes, el proceso de la pasteurización. -
 Louis Pasteur de igual forma rechazó totalmente la teoría de la generación espontanea, pues sus muchos experimentos y estudios científicos, lo llevaron a negar esta teoría a proponer muchas otras, dando paso a una nueva era para la microbiología, llamada "la edad de oro de la microbiología"
Louis Pasteur de igual forma rechazó totalmente la teoría de la generación espontanea, pues sus muchos experimentos y estudios científicos, lo llevaron a negar esta teoría a proponer muchas otras, dando paso a una nueva era para la microbiología, llamada "la edad de oro de la microbiología" -
 El doctor Ferdinand Cohn, dedic parte de su vida al estudio de los microorganismos de las algas. En el año 1866 fundó el primer Instituto de Fisiología vegetal, dando paso de igual forma a la creación de la bacteriología, una rama de la microbiología. Así fue como en 1872 descubrió que existen distintos tipos de microorganismos con formas y órganos diferentes.
El doctor Ferdinand Cohn, dedic parte de su vida al estudio de los microorganismos de las algas. En el año 1866 fundó el primer Instituto de Fisiología vegetal, dando paso de igual forma a la creación de la bacteriología, una rama de la microbiología. Así fue como en 1872 descubrió que existen distintos tipos de microorganismos con formas y órganos diferentes. -
 El médico Robert Koch, dio grandes aportes al estudio de la microbiología, uno de los mas importantes fue descubrir el bacilo de la tuberculosis. El principal trabajo de Koch los "postulados de Koch" dieron un gran avance para todos los microbiólogos de la época e incluso hoy en día se utilizan para los estudios de los microorganismos.
El médico Robert Koch, dio grandes aportes al estudio de la microbiología, uno de los mas importantes fue descubrir el bacilo de la tuberculosis. El principal trabajo de Koch los "postulados de Koch" dieron un gran avance para todos los microbiólogos de la época e incluso hoy en día se utilizan para los estudios de los microorganismos. -
 Alexander Fleming, médico y científico británico, se le atribuye la creación de la penicilina, antibiótico y antimicótico, dió paso a la microbiología moderna y al conocimiento acerca de la inmunidad, la replicación y uso de los microorganismos para combatir las enfermedades.
Alexander Fleming, médico y científico británico, se le atribuye la creación de la penicilina, antibiótico y antimicótico, dió paso a la microbiología moderna y al conocimiento acerca de la inmunidad, la replicación y uso de los microorganismos para combatir las enfermedades.
Looking for a timeline maker?
Create timelines for projects, roadmaps, history, lessons, legal cases, and stories with Timetoast. Timetoast is a timeline maker for work, school, research, and stories.